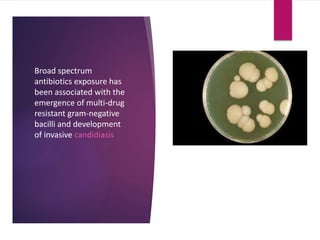
Broad spectrum
antibiotics exposure has
been associated with the
emergence of multi-drug
resistant gram-negative
bacilli and development
of invasive candidiasis

The document provides an overview of antimicrobial stewardship programs and antibiotic resistance. It discusses how antibiotic overuse has led to increased resistance [1]. Antimicrobial stewardship programs aim to optimize antibiotic use and slow resistance through coordinated actions [2]. The core elements of effective programs include leadership commitment, accountability, drug expertise, tracking antibiotic use and resistance, reporting on improvement efforts, and education [3]. Targeted strategies are needed given the unique challenges of prescribing antibiotics for neonatal intensive care patients. Bundles of evidence-based practices can help reduce healthcare-associated infections like CLABSIs in the NICU.





























![Antimicrobial Stewardship Goals
stewardship program with strict
implementation of infection control
measures leading to sustained
reduction in [CDI] cases](https://image.slidesharecdn.com/57718c12-7d94-4476-a94c-722cc89f693b-160826104617/85/Antimicrobial-Stewardship-Heba-Abdallatif-BCPS-30-320.jpg)